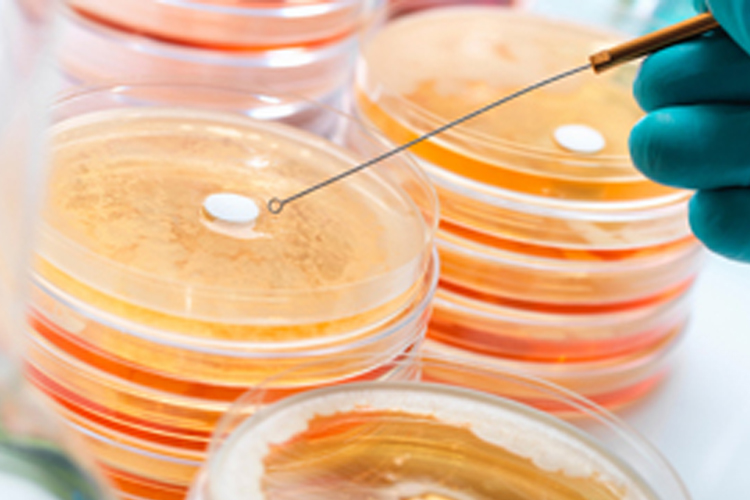
壓花輪檢測

表面波紋度測(cè)量

檢測(cè)優(yōu)勢(shì)
1、初檢樣品小樣,初檢期間不收取任何費(fèi)用。
2、健明迪檢測(cè)國家高新技術(shù)企業(yè)。
3、健明迪檢測(cè)所出具的食品檢測(cè)報(bào)告認(rèn)可,支持掃碼查詢真?zhèn)巍?/p>
4、健明迪檢測(cè)多家實(shí)驗(yàn)室分支,支持上門取樣,也支持寄樣檢測(cè)。
5、檢測(cè)周期全,檢測(cè)費(fèi)用低,實(shí)驗(yàn)方案齊全。
檢測(cè)流程
1、寄樣。(咨詢工程師提交檢測(cè)需求,然后給我們郵寄樣品)
2、初檢樣品。(收到樣品之后,初檢樣品,制定詳細(xì)的實(shí)驗(yàn)方案)
3、報(bào)價(jià)。(初檢之后,根據(jù)實(shí)驗(yàn)復(fù)雜程度以及客戶檢測(cè)需求進(jìn)行報(bào)價(jià))
4、雙方確定,簽訂保密協(xié)議,開始實(shí)驗(yàn)。(嚴(yán)格保護(hù)客戶隱私)
5、結(jié)束實(shí)驗(yàn)。(7-10個(gè)工作日完成實(shí)驗(yàn))
6、郵寄檢測(cè)報(bào)告,后期服務(wù)。
檢測(cè)標(biāo)準(zhǔn)參考
GB/T 7220-2004產(chǎn)品幾何量技術(shù)規(guī)范(GPS)表面結(jié)構(gòu) 輪廓法 表面粗糙度 術(shù)語 參數(shù)測(cè)量
GB/T 15757-2002產(chǎn)品幾何量技術(shù)規(guī)范(GPS)表面缺陷術(shù)語、定義及參數(shù)
GB/T 16747-2009產(chǎn)品幾何技術(shù)規(guī)范(GPS) 表面結(jié)構(gòu) 輪廓法 表面波紋度詞匯
GB/T 32643-2016平板顯示器基板玻璃表面波紋度的測(cè)量方法
JB/T 9924-2014磨削表面波紋度
T/CSAE 48-2016汽車用薄鋼板表面波紋度
檢測(cè)樣品:鋼板等
檢測(cè)項(xiàng)目:表面波紋度測(cè)量
檢測(cè)周期:7-15個(gè)工作日(參考周期)
檢測(cè)項(xiàng)目:表面波紋度測(cè)量,檢測(cè)標(biāo)準(zhǔn)參考:GB/T 32643-2016平板顯示器基板玻璃表面波紋度的測(cè)量方法。健明迪檢測(cè)國家高新技術(shù)企業(yè),檢測(cè)資質(zhì)齊全,實(shí)驗(yàn)室儀器先進(jìn),真正的一站式檢測(cè)服務(wù)。